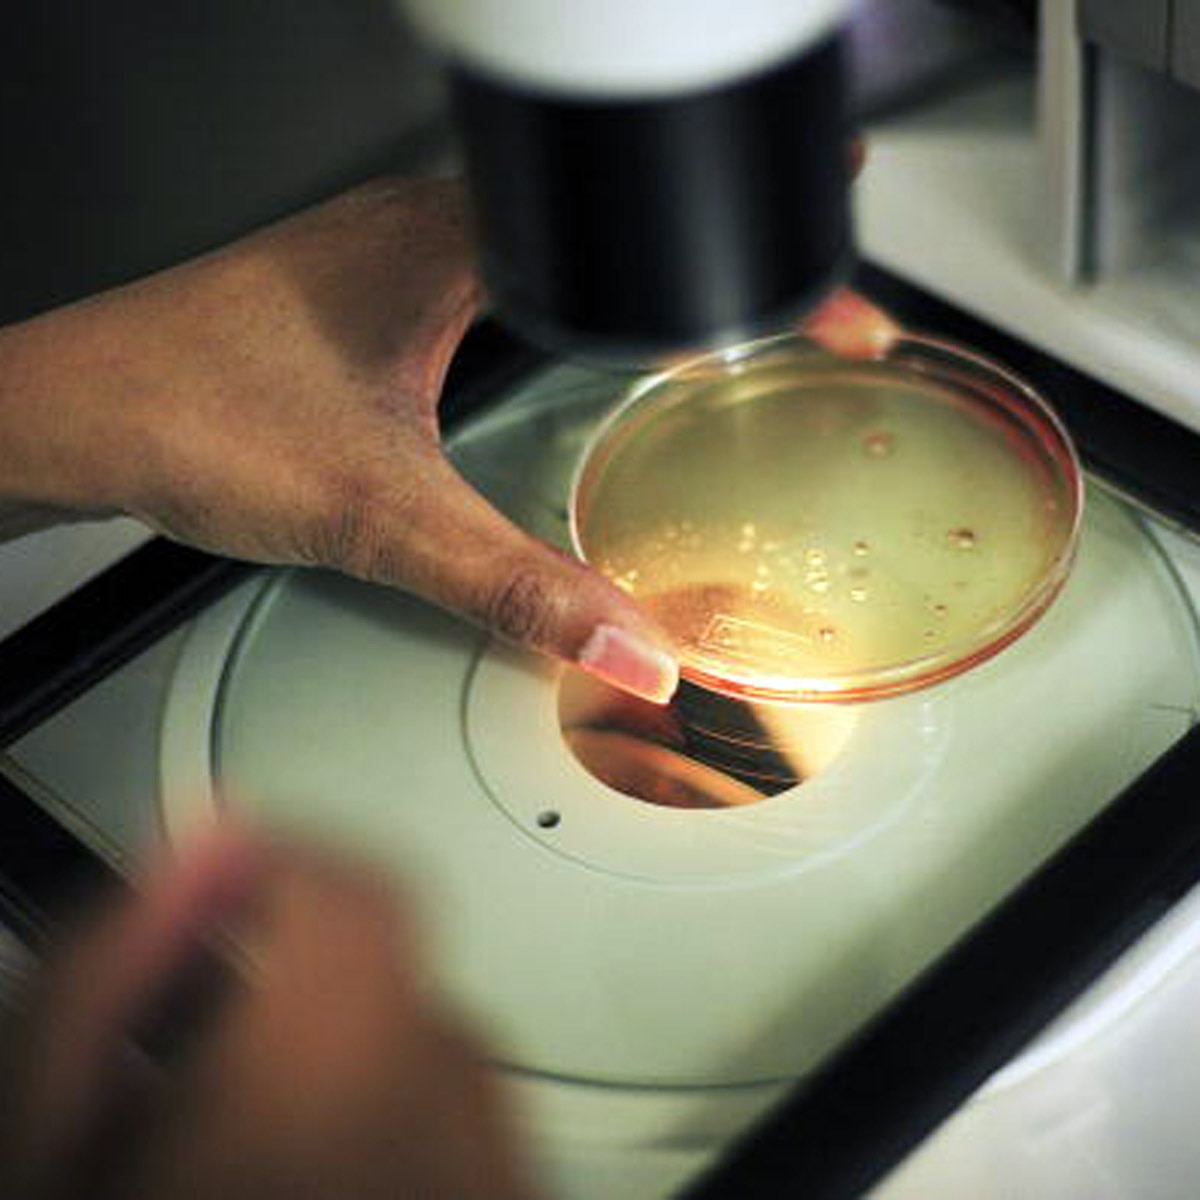
doctor secretly impregnate

डॉक्टर ने Sperm बदल सैकड़ों महिलाओं को किया प्रेग्नेंट, ऐसे हुआ खुलासा
कनाडा के एक फर्टिलिटी डॉक्टर के ऊपर कई महिलाओं ने धोखाधड़ी का केस दर्ज करवाया. महिलाओं का कहना है कि डॉक्टर ने स्पर्म बदल कर अपने स्पर्म द्वारा उन्हें प्रेग्नेंट कर दिया. यानी कि डॉक्टर ने बिना बताए महिलाओं के एग्स को अपने स्पर्म से फर्टिलाइज कर उन्हें प्रेग्नेंट कर दिया. इसी केस में अब डॉक्टर पर भारी भरकम जुर्माना लगा है.
(आरोपी डॉक्टर- Norman Barwin)
वाशिंगटन पोस्ट के मुताबिक, डैन और डेविना डिक्सन ने संतान के लिए कनाडा में फर्टिलिटी डॉक्टर नॉर्मन बारविन की मदद ली थी. इसके बाद डेविना ने 1990 में एक बच्ची को जन्म दिया. उन्होंने उसका नाम रेबेका रखा.
(सभी फोटो- गेटी)
दो दशक से अधिक समय तक, डिक्सन परिवार का मानना था कि रेबेका के जैविक पिता डैन ही हैं. लेकिन इस दशक के मध्य में किए गए एक डीएनए टेस्ट से पता चला कि रेबेका वास्तव में फर्टिलिटी डॉक्टर चिकित्सक की संतान थी, जिसके पास वो करीब 20 साल पहले डेविना को ले गया था.
डैन को पूरा मामला समझ आ गया और उसने 2016 में, बारविन पर मुकदमा दायर कर दिया. बारविन ने दशकों तक कनाडा में एक फर्टिलिटी क्लिनिक संचालित किया था. ऐसे में डैन की तरह दूसरे लोग भी डॉक्टर के खिलाफ़ केस दर्ज कराने लगे, क्योंकि उसने कई महिलाओं के साथ स्पर्म की धोखेबाजी की थी.
अब तक 100 से अधिक लोग सामने आ चुके हैं, जिन्होंने आरोप लगाया कि डॉक्टर ने अपने स्पर्म द्वारा उन्हें प्रेग्नेंट किया. रेबेका सहित करीब 17 लोगों ने डीएनए टेस्ट के माध्यम से पता लगाया है कि फर्टिलिटी डॉक्टर बारविन ही उनके बच्चों के जैविक पिता हैं और उन्हें "बारविन बेबी" के रूप में जाना जाता है. जबकि 80 से अधिक अन्य अपने जैविक पिता की पहचान नहीं जानते हैं.
ऐसे में बीते दिनों जब मामला बिगड़ा तो डॉक्टर नॉर्मन बारविन को हर्जाने के तौर पर पीड़ितों को 10.7 मिलियन डॉलर (करीब 79 करोड़ रुपये) देने के लिए कहा गया. हालांकि, कोर्ट में आरोपी और डॉक्टर के इस प्रस्तावित समझौते को अभी तक मंजूरी नहीं मिली है. नवंबर में कोर्ट इस केस की समीक्षा करेगा.
बता दें कि डॉक्टर की इस करतूत का खुलासा तब हुआ आईवीएफ से पैदा हुई रेबेका ने बड़े होकर पैरेंट्स से अपनी आंखों के अलग रंग होने को लेकर सवाल किया. कहा गया कि नीली आंखों वाले दंपति के लिए भूरे रंग के बच्चे का होना असामान्य है. परिवार में ऐसा पहली बार हुआ था. जिसके बाद रेबेका डॉक्टर से मिली और डीएनए टेस्ट करवाया. टेस्ट में पुष्टि हुई कि रेबेका के जैविक पिता डैन नहीं हैं.
अनुमान है कि 1973 से 2012 के बीच, बारविन ने लगभग 500 महिलाओं को प्रेग्नेंट किया, जिनके बच्चे हुए. इसलिए पीड़ितों की संख्या 200 से अधिक लोगों से आगे बढ़ सकती है.
रेबेका के केस के बाद डॉक्टर बारविन से ट्रीटमेंट करवाए कई लोगों ने अपने बच्चों का डीएनए टेस्ट करवाया. इसमें कई मामले ऐसे थे जिसमें स्पर्म बदले जाने की बात सामने आई. इनमें से ज्यादातर के जैविक पिता खुद डॉक्टर निकला. अब डॉक्टर के ऊपर पुलिस केस किया गया है, जिसके बाद उसे सजा भी हो सकती है.